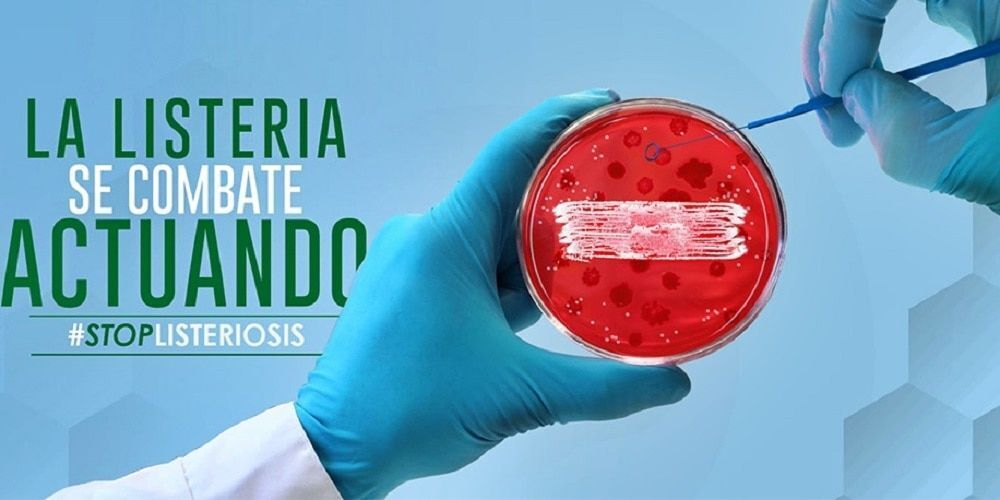

La Junta crea una web para ofrecer toda la información sobre el brote de listeriosis
La nueva web ofrecerá todos los datos e información práctica sobre la enfermedad
El Gobierno de Andalucía ha lanzado la página web alertalisteriosis.es, que informa a los ciudadanos acerca de las actuaciones que la Consejería de Salud y Familias ha llevado a cabo desde la activación de la alerta sanitaria por el consumo de carne mechada de la empresa Magrudis, decretada el pasado 15 de agosto, y que recopilará todos los datos sobre el brote de listeriosis. El lanzamiento de esta web responde al compromiso de transparencia que el Gobierno de Andalucía se ha marcado desde que se detectó la aparición del brote.
La web lleva el lema 'La listeria se combate actuando' y ofrece, además, información práctica para las personas afectadas por esta infección, una cronología de las decisiones más importantes que la Consejería de Salud y Familias ha adoptado desde que lanzó la primera alerta, así como un mapa interactivo en el que los ciudadanos pueden comparar el nivel de supervivencia del brote en Andalucía en comparación con los acontecidos en otras partes del mundo en los últimos años.
Este mapa interactivo pone de manifiesto que en el reciente brote registrado en la comunidad autónoma andaluza la mortalidad no ha pasado del 1,4%, mientras que en los casos registrados en Estados Unidos en 2011 este índice llegó al 22%, y en Francia (2013) se elevó al 34%.
La web incorpora una serie de datos relevantes acerca del tratamiento de la enfermedad en Andalucía, en la que se han implicado 96.466 profesionales del Servicio Andaluz de Salus (SAS). Una de las actuaciones preferentes de la Consejería de Salud y Familias ha sido la atención a las mujeres embarazadas, especialmente vulnerables ante la listeria: el protocolo específico para ellas logró poner bajo control médico a más de 31.000 mujeres en periodo de gestación en menos de dos semanas.
El consejero de Salud y Familias, Jesús Aguirre, ha invitado a los ciudadanos a consultar la página web alertalisteriosis.es, en la que se recoge toda la información que existe en torno a la enfermedad, y ha lanzado un mensaje de tranqulidad a los andaluces, al destacar que el trabajo realizado por los profesionales para localizar y hacer frente al brote de listeriosis.
En el dispositivo contra la listeria ha participado una red de 48 hospitales públicos y 25 privados de toda la comunidad autónoma. Otras cifras que destaca la web es el número de establecimientos inspeccionados por la Junta de Andalucía para minimizar el riesgo de listeria: han sido 969 de 105 municipios. Destacan también los datos de productos inmovilizados por sospecha de contaminación: 14.000 kilogramos.
alertalisterioris.es incorpora una serie de recomendaciones para prevenir la listeria y los comunicados de prensa emitidos por la Consejería con motivo del brote, así como el teléfono de Salud Responde (955545060) y su correo electrónico (saludresponde@juntadeandalucia.es) para que los ciudadanos realicen sus consultas sobre la listeria. La Junta de Andalucía mantendrá actualizada esta web con las novedades sobre el brote de listeria.
